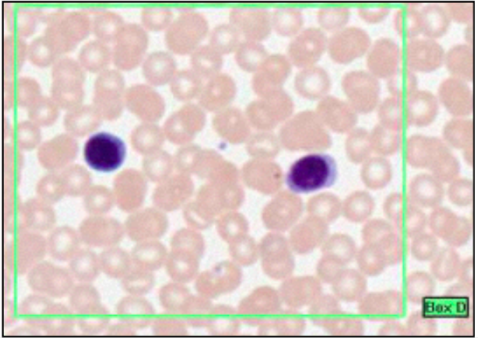
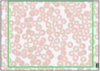

LYMPH NODULE WITHIN SUBMANDIBULAR GLAND

SIMPLE COLUMNAR
- height > width
- oval nucleus
- longer axis perp. to base of cell
- often microvilli or cilia at apical membrane
- GUT ENTEROCYTES and RESPIRATORY TRACT
left = gallballder

GI TRACT LAYERS (x4)
- mucosa - innermost. epithelium (folded), connective tissue (lamina propria - w/ lymphoid tissue), smooth muscle ring (muscularis mucosa)
- sub-mucosa - loose connective tissue, glands and lymphoid tissue, many blood vessels, meissner’s plexus (enteric nervous sytem)
- external muscle coat (muscularis externa)- 2 layers of smooth muscle - persistalis -auerbach’s plexus (enteric nervous system)
- serosa - simple squamous epithelium

LOOP OF HENLE (PAS)
- mostly @ medulla
- thick/straight descending, thin loop, thick ascending
- thick descend = similar to proximal tubule
- thick ascend = similar to distal tubule
- longest thin loop penetrate deepest to medulla when glomerulus = cortico-medulla junction
- thin descending portion = low permeability to ions and urea, high permeability to water
- thin ascending portion retains water, reabsorption Na+ and Cl-
- this produces dilute/hypotonic filtrate but a hypertonic interstitium
- vasa recta (straight capillaries) run alongside tubules
this slide - thick and thin limbs and vasa recta

PITUITARY GLAND
- anterior / posterior
POSTERIOR - neuronal origin, down growth of brain, pituitary stalk to median eminence of mid-brain @ floor of V3
supra optic and para-ventricular nuclei
- oxytocin
- vasopressin
ANTERIOR (TROPHIC) - epithelial origin. roof of primitive gut. adheres @ anterior border of posterior pituitary and surrounds stalk (pars tuberalis)
- growth hormone
- thyroid stimulating hormone
- follicle stimulating hormone

STRATIFIED SQUAMOUS
- mouth, throat, oesophagus, anus, vagina
- cells replaced from below
- stem cells (mitosis capable) at basal layer
- sloughed off from top
this slide = moist non-keratinised stratified squamous epithelium at mouth
(moist from glandular secretion)

CONNECTIVE TISSUE - INTRO
- extracellular fibre scaffold - COLLAGEN/ELASTIN
- jelly-like matrix - hydrophilic polysaccharide polymer - GAG - glycosaminoglycans
- GAG - synthesises @ epithelial cells, muscle, cartilage, bone
- COLLAGEN/ELASTIN synthesised by fibroblast

VEINS (TOP LEFT x2)
- same layers as arteries, but thinner and poor boundaries
- irregular outline, large lumne (therefore same blood at lower pressure)
- wider lumen than arterioles (but slower flow) therefore same volume/sec

LIP 1
- mucosa = typical of mouth (stratified squamous non-keratinising epithelium - SSNKE)
- @ margin, abrupt transer to skin (stratified squamous keratinising epithelium - SSKE)
- connective tissue (sub-mucosa) - collage and elastin
- deeper layers - glands and striated skeletal muscle (change shape of oral cavity)
- small blood vessl @ sub-mucosa help keep moist
What is this?

ALCIAN BLUE
- GAG-rich
- mucous
- mast cells
- cartilage
BLUE

SKELETAL MUSCLE LONGITUDINAL
- each skeletal muscle fibre = hundreds of myoblasts fused to syncitium
- each fibre = many nuclei under plasmalemma at side of fibre - DISTINGUISHING POINT
this slide -tongue
n.b. small fascicles usuall denote smaller motor units = fine control

EPITHELIAL SQUAMES
- in menstrual cycle surface cells accumulate glycogen and flake off
- desquamated cells rupture and bacteria generate lactic acid
- low pH at vagina
pale green cells - outermost layer, predominate at first half of menstrual cycle
pink cells - deeper layer

SKELETAL MUSCLE (TRANSVERSE)
- loosely aggregated to fasciuli by PERIMYSIUM
- nuclei at periphery of fibre
SKELETAL MUSCLE INDIVIDUALLY INNERVATED IN MOTOR UNITS
MITOCHONDRIA BETWEEN MUSCLE FIBRILS WITH MUSCLE FIBRES
MAY SEE GLYCOGEN AND LIPID DROPLETS

GI FORMATIVE 3
- serous glands @ bottom
- mucus glands @ top
- this is mixed
therefore this is a submandibular gland
(mixed = submandibular)

NOSE (H&E AND ALCIAN BLUE)
- mucous/cartilage - blue
- central bone plate - pink
- respiratory epithelium either side
- thin walled blood vessels between epithelium and bone
- mucous containing goblet cells stained bright blue

EPIGLOTTIS 2
- SSNKE

EPITHELIA
- barries
- single layer = simple
- multi layer = stratified
- stratified = protection

LYMPHOCYTE SIZE
- small = 5 microns
- little cytoplasm as dormant and not fully differentiated
- metabolically inactive
- minimal rER

FOLLICULAR PHASES
- cyclical
- synthesise thyroglobulin and store within follicle
- after dormant period re-sorb and break down colloid and release active hormone (T4) into bloodstream

GLOMERULAR TUFT (PAS)
- arise from vascular pole of glomerulus = entrance afferent and exit efferent
- in this angle lies a distal loop of nephron with palisade of macula densa
- capillary loop surrounded by podocyte
- surrounded by urinary space - separates glomerulus from bowman’s capsule
- arrow to distal tubule
- MACULA DENSA - around blood vessels regulate blood flow, provides framework for glomerulus.

EPIGLOTTIS
- @ posterior of tongue
- boundary of oropharynx and laryngeal pharynx
- mostly SSNKE
- lower part posterior - pseudo-stratified columnar ciliated epithelium (respiratory)
contains:
- elastic cartilage plate
- lymph nodules (submucosa)
- salivary glands (submucosa)
Box A = buccal surface - faces mouth
LYMPHOCYTES
- small cells with dark stained nucleus and little cytoplasm
- B and T are indistinguishable
- immature are bigger than RBC, smaller than granulocytes
- mature roughly equal size to granulocyte

GROWING LONG BONE
- increase in length by adding bone at epiphyseal plate
- additional bone on outside of shaft
- ossification starts at diaphysis
- single epiphyseal growth plaet at distal phalanges of fingers and toes
- carpal and tarsal bones last to ossify @ 7/8yo

MEMBRANOUS BONES & OSTEOBLATS
- some skull bones formed by direct deposit of bone in condensed mesenchyme = intra-membranous ossification
- easier to recognise osteoblasts
- larger than osteocyte
- dark blue/purple cytoplasm (as large amounts of RNA)
trapped within bone when they lay down new bone - form osteocytes